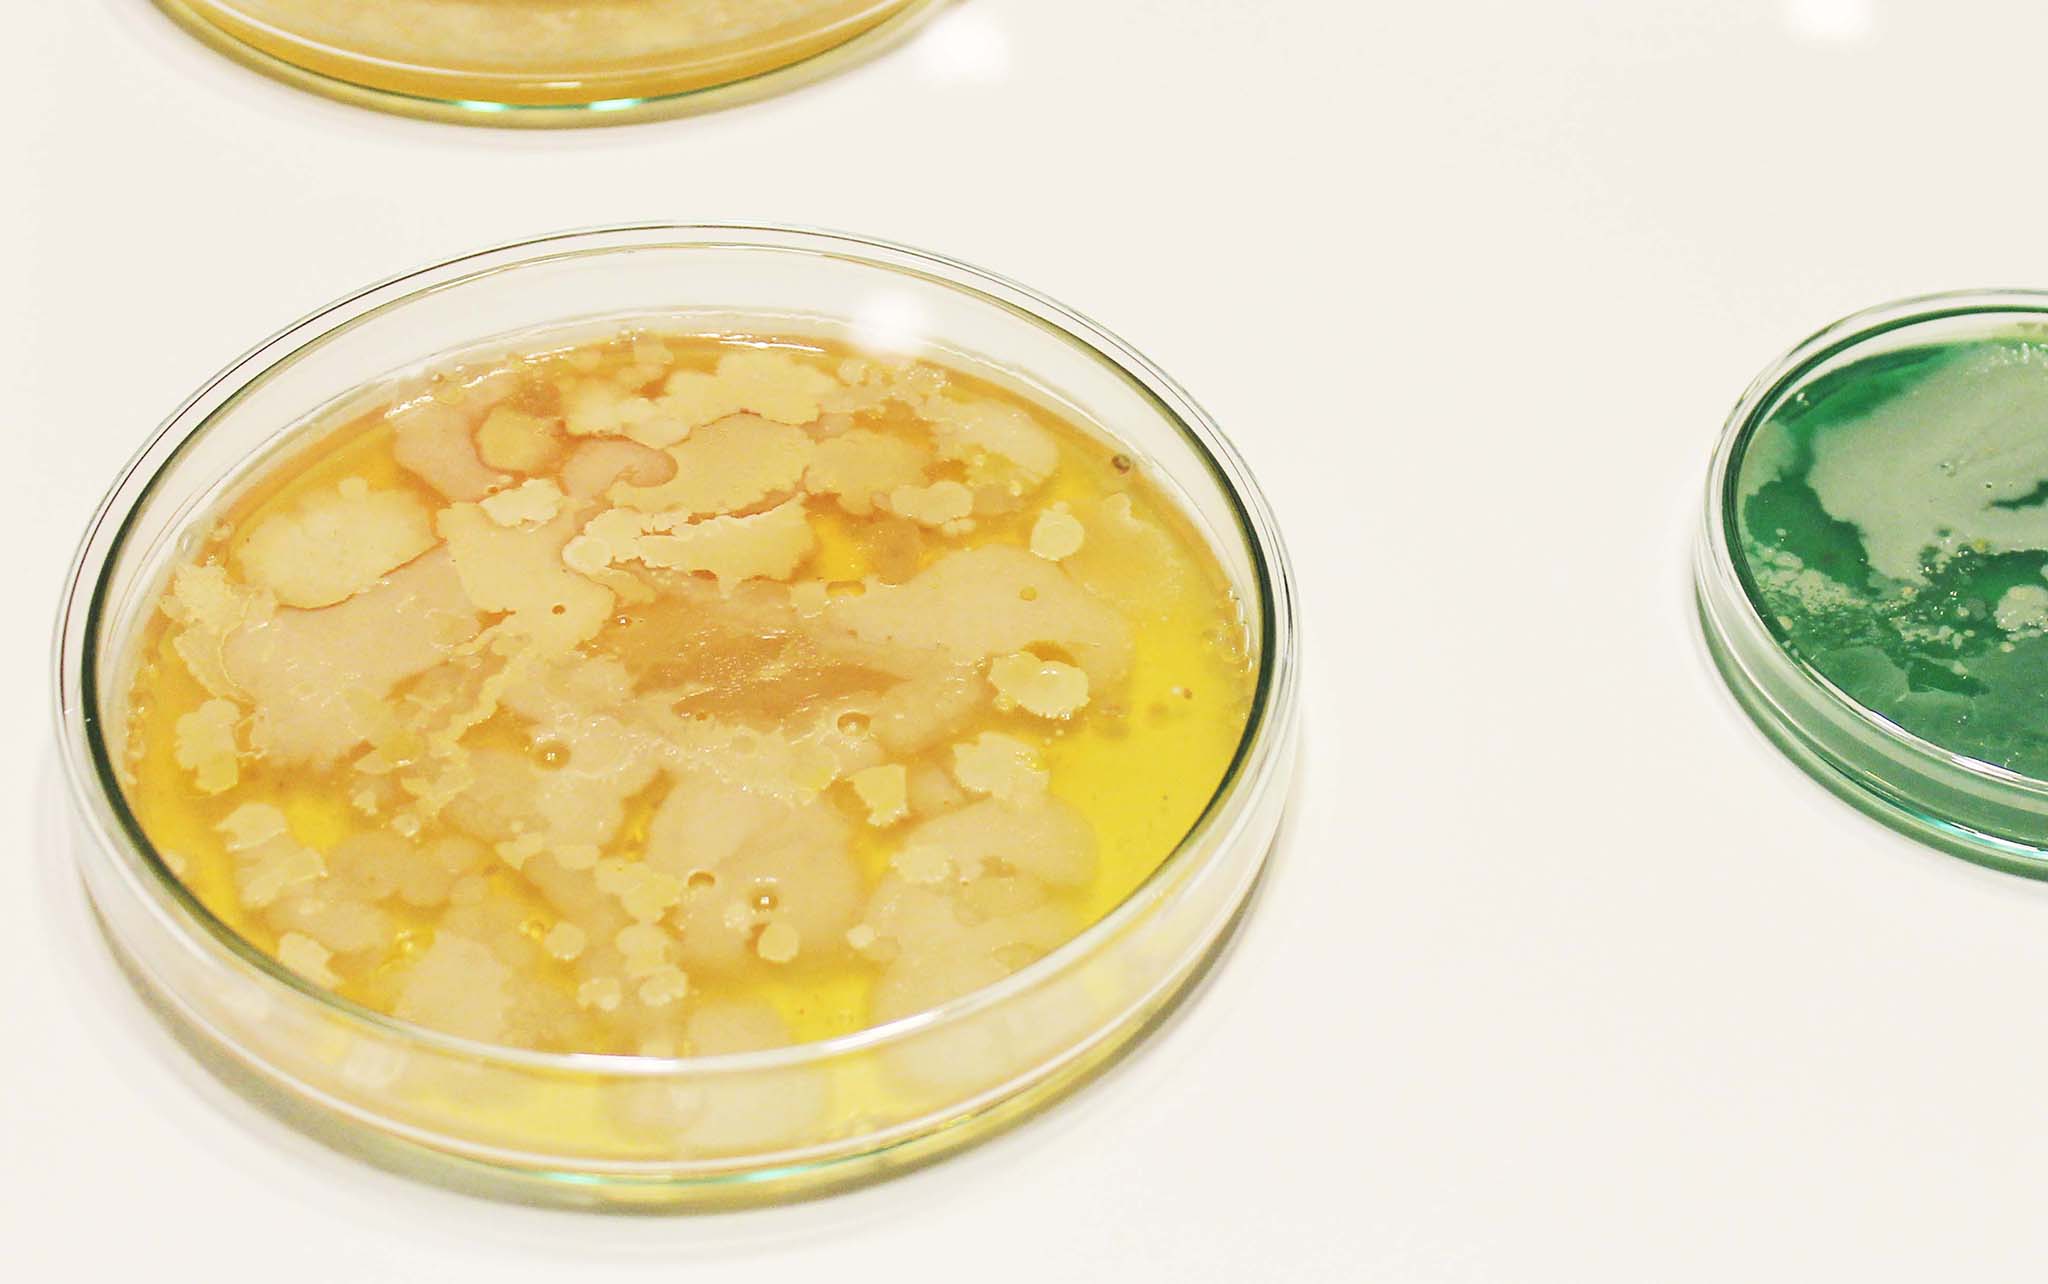
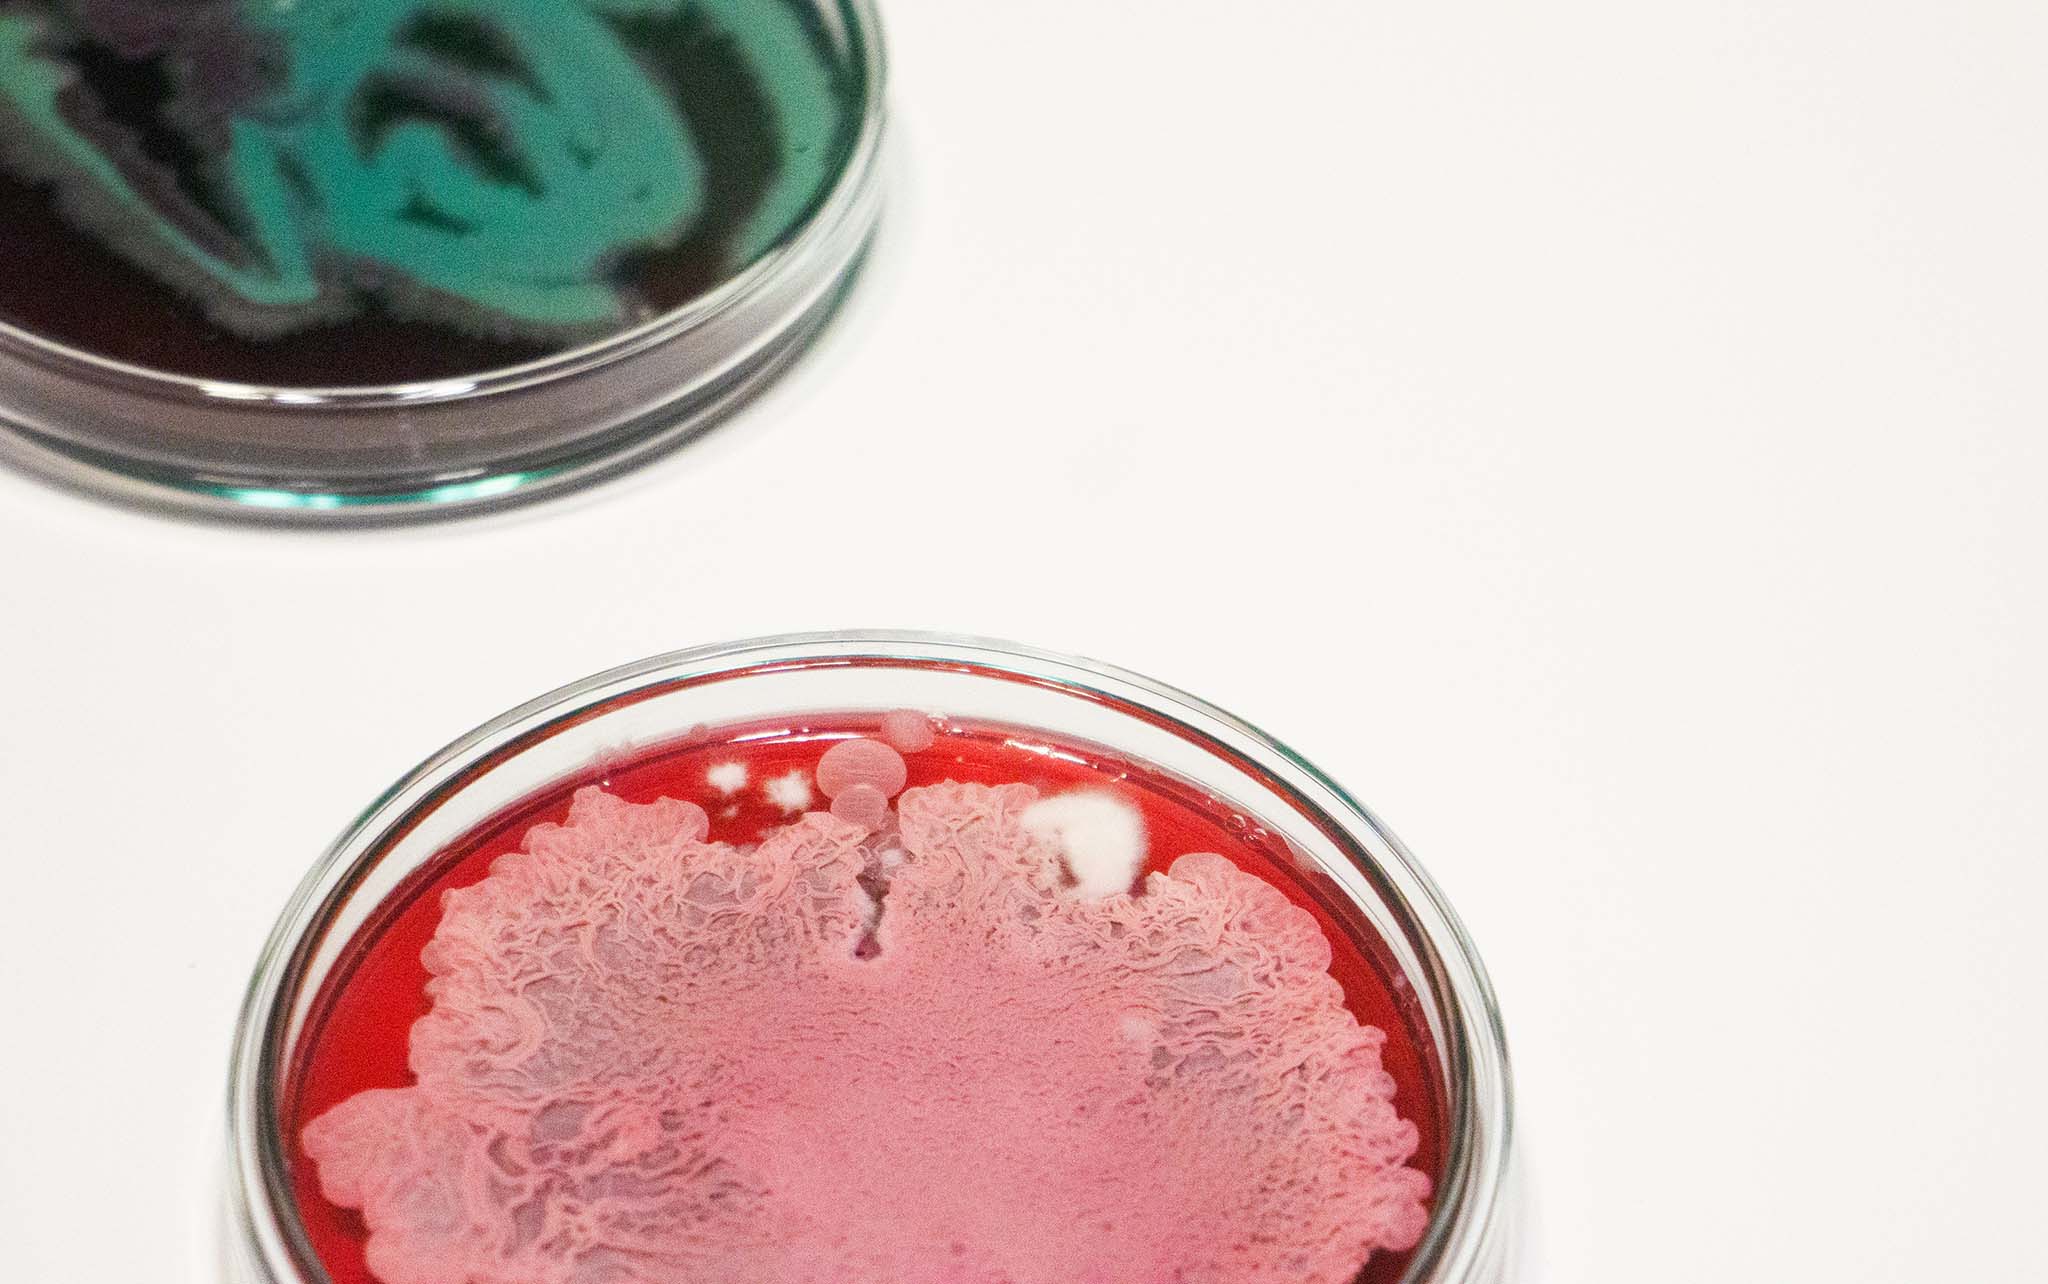
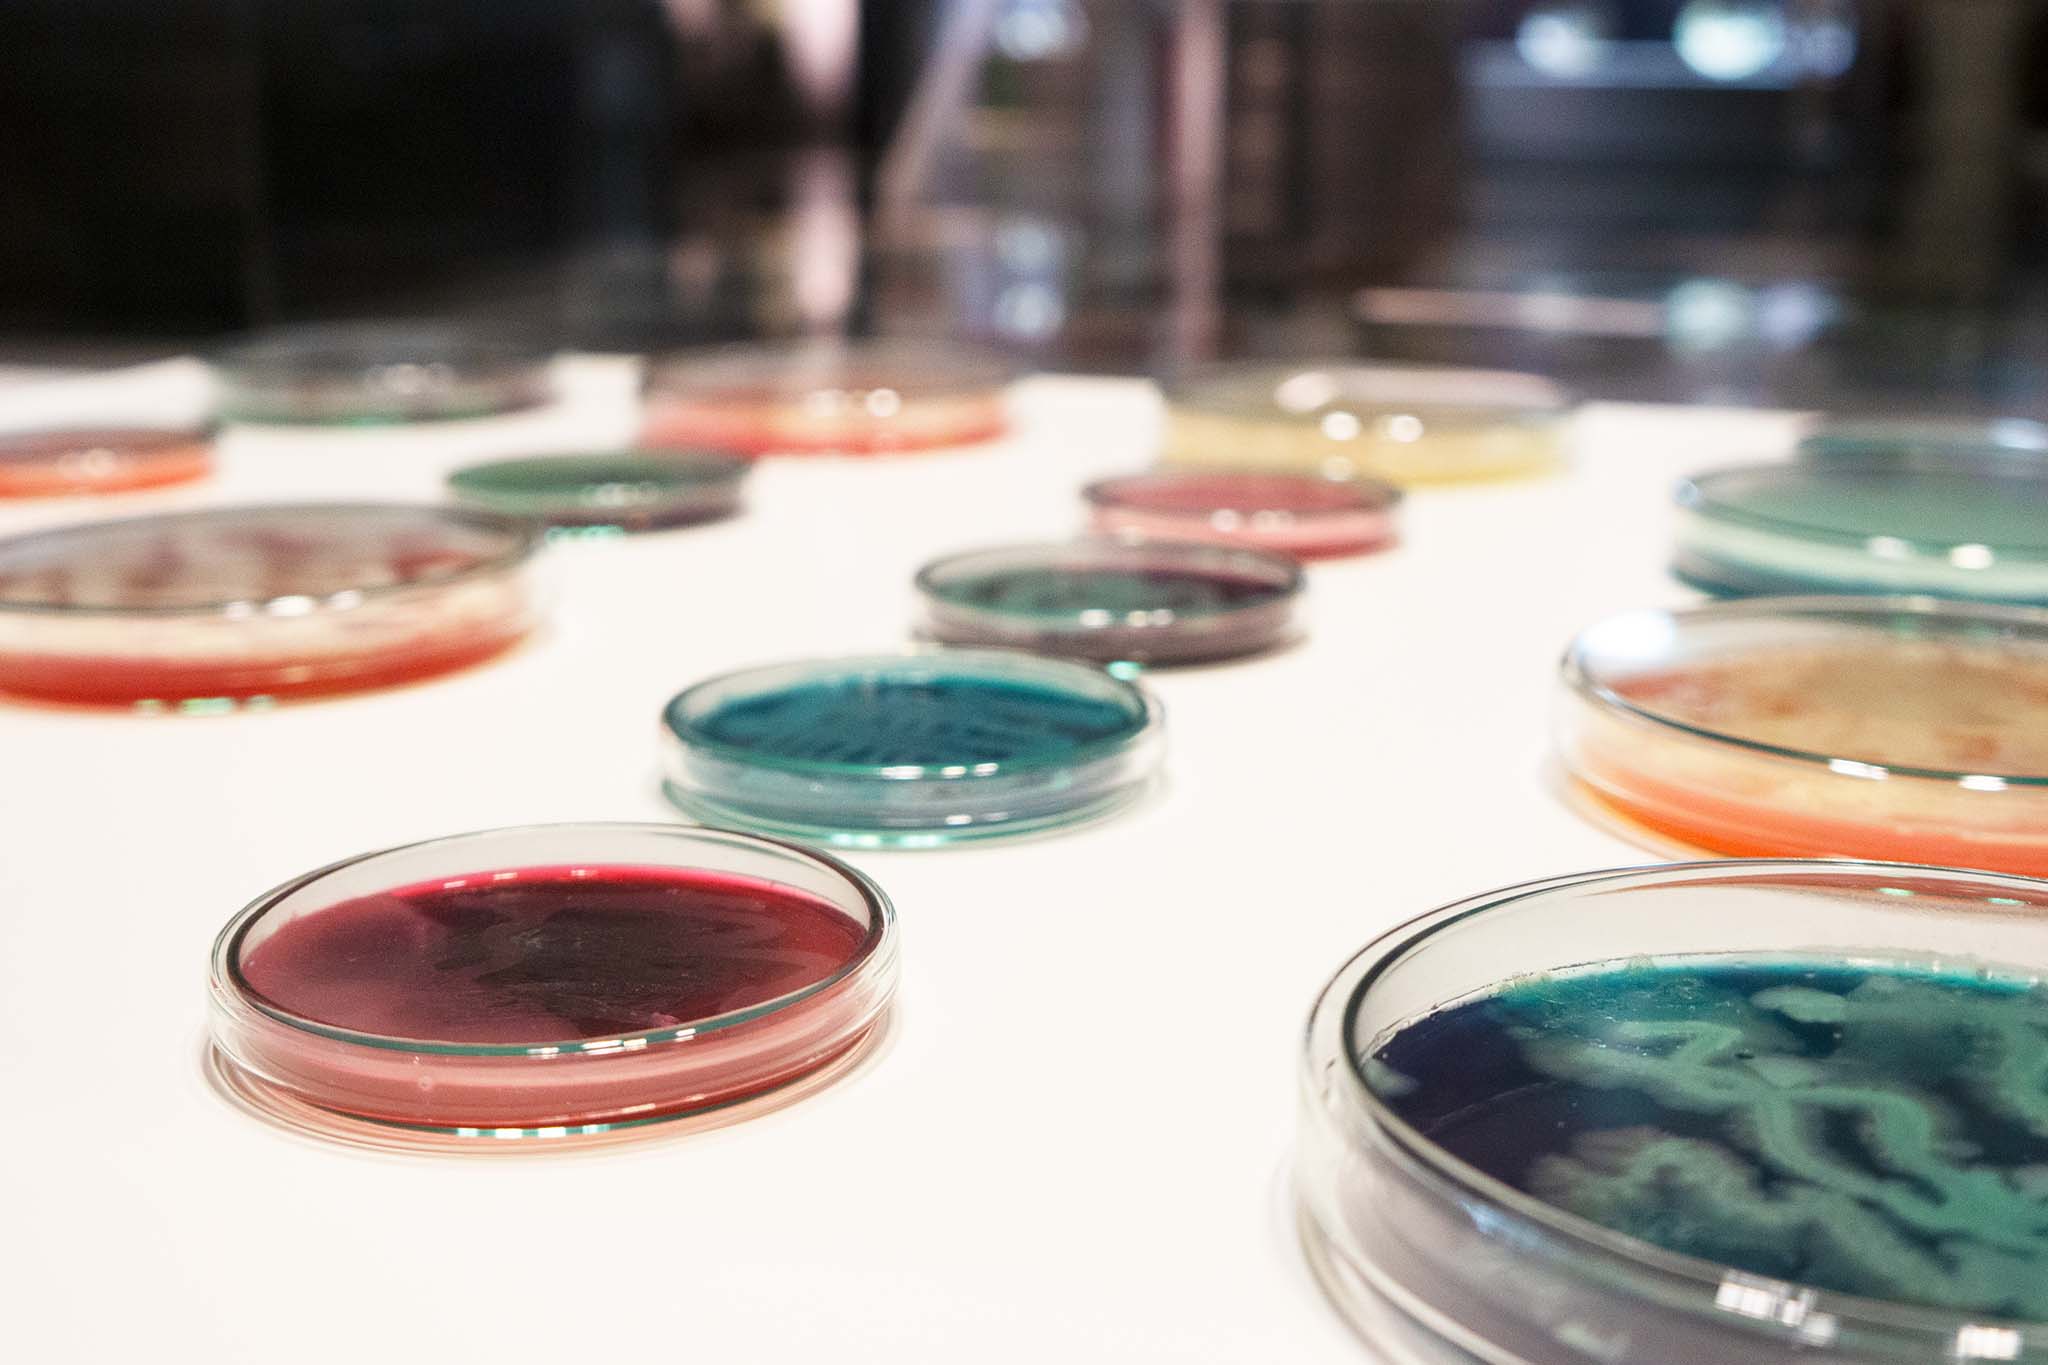
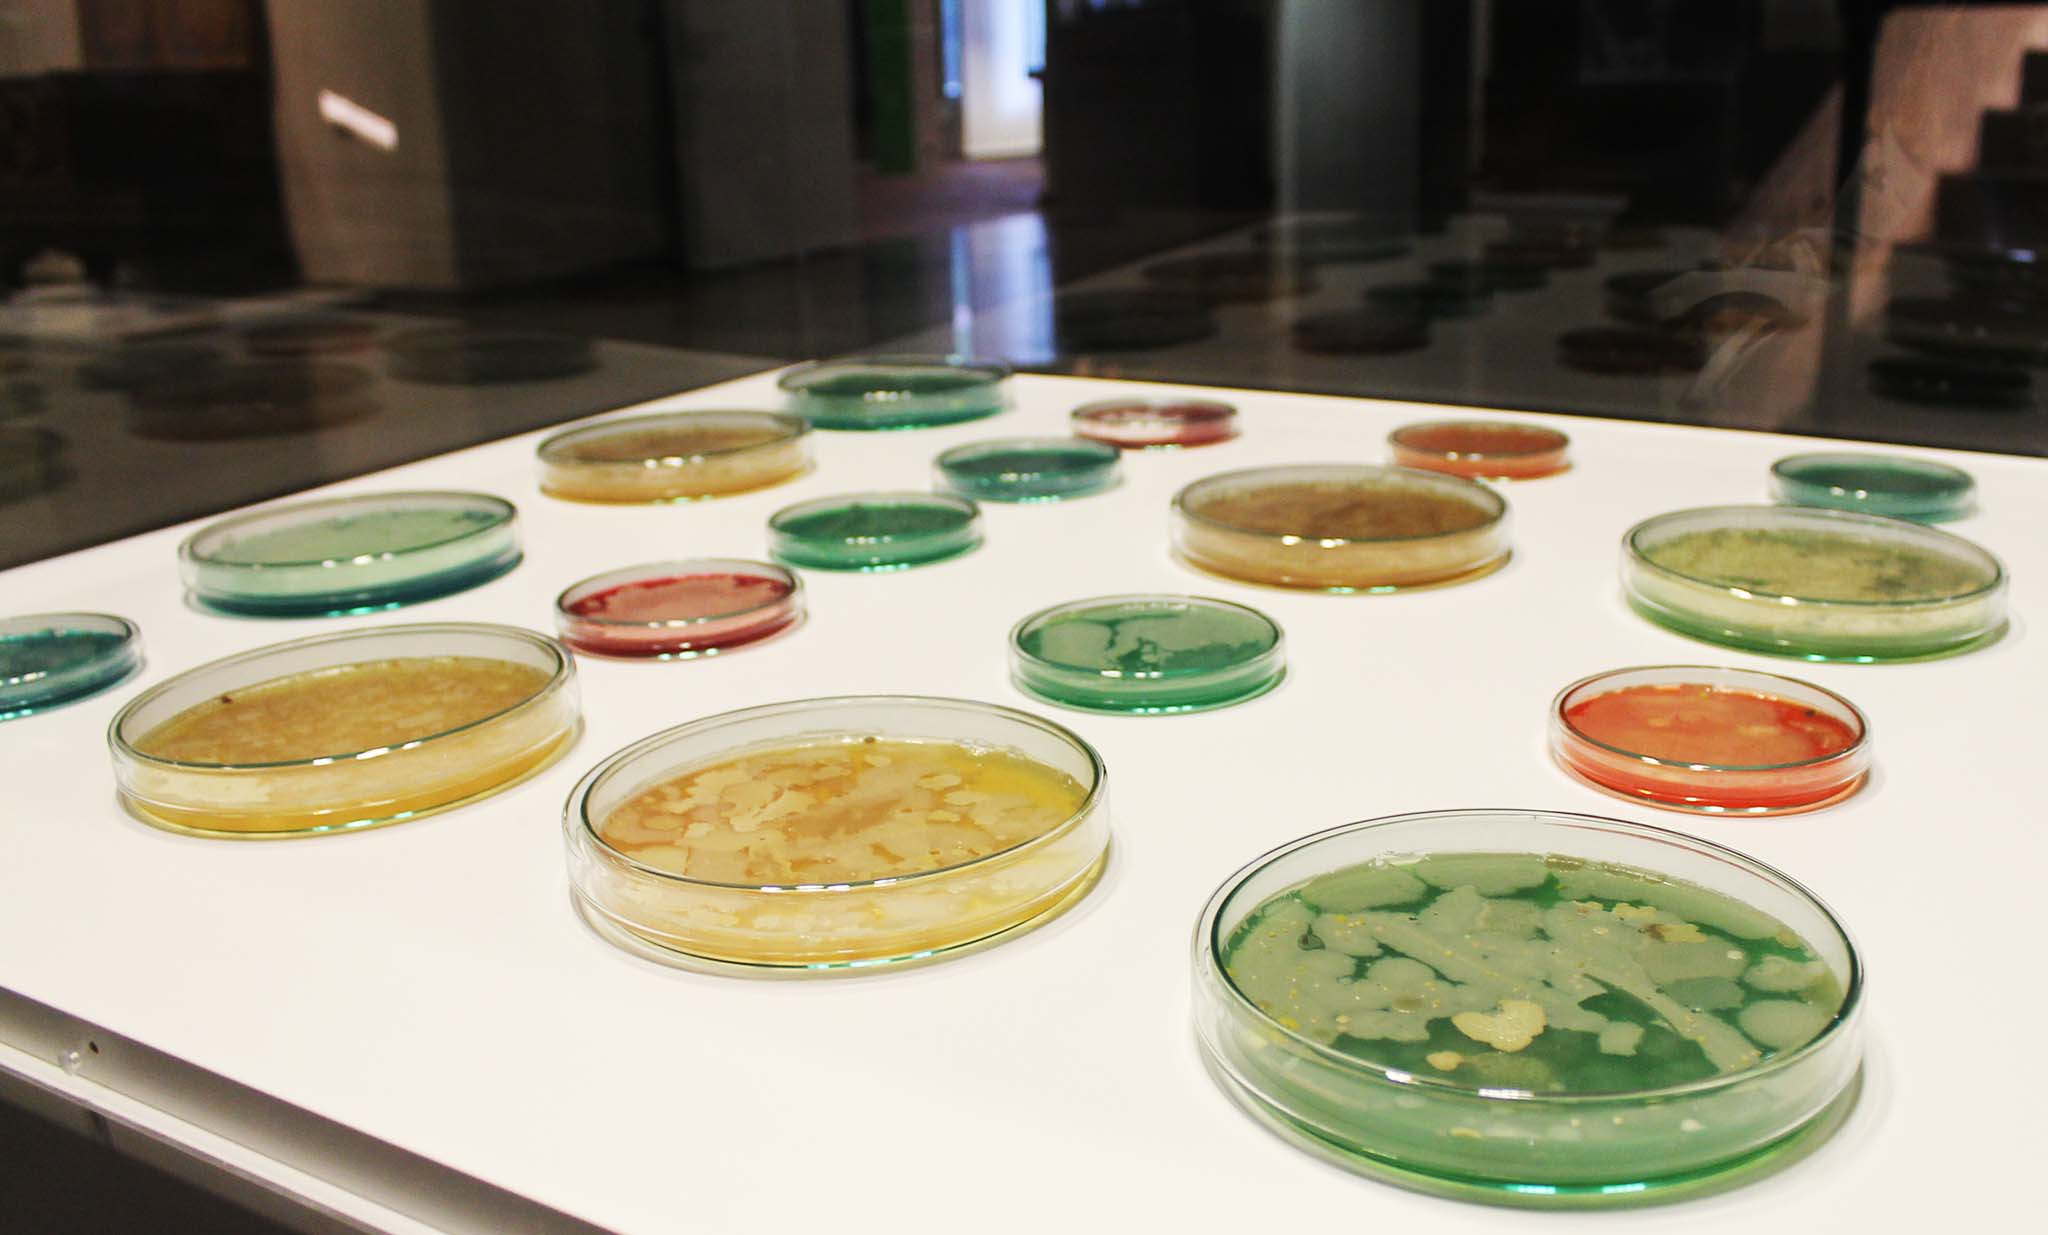

MICRO GOES MACRO GOES KGM
Was hätte ein „Design auf Zeit” im KGM verloren, in dem Zeit normalerweise stillgestellt wird? Die Objekte sollen hier so gut es geht vor dem Verfall bewahrt werden – dazu werden sie zunächst in der sogenannten „Entwesungskammer” von allen potentiell schädlichen Organismen befreit. Doch nicht alle Schädlinge lassen sich restlos beseitigen. Einige Bakterienarten leben aller Maßnahmen zum Trotz auch im Museumraum weiter.
Mithilfe von Petrischalen, einem Agarnährboden und einigen Bakterienproben aus dem Museum wird das „geheime Leben” der Museumsbakterien aufgedeckt. Es wird also nichts neues in das KGM gebracht, sondern mit dem gearbeitet, was ohnehin bereits vorhanden ist: Ob auf dem Kuppelreliquiar, der Eingangstür, der Vase von Louis Comfort Tiffany oder dem Schlüsselbund des Museumsleiters.
„Temporary design“ in the context of the KGM doesn’t really fit, since this is a place where time is usually suspended. The objects here are to be preserved from decay as best as possible – therefore they are first freed from all potentially harmful organisms in the so-called „disinfestation chamber“. However, not all pests can be completely eliminated. Despite all the measures taken, some types of bacteria continue to live in the museum. With the help of Petri dishes, an agar culture medium and some bacterial samples from the museum, the „secret life“ of the museum bacteria can be uncovered. So nothing new is brought into the KGM, rather work is done with what is already there: whether on the dome reliquary, the entrance door, the vase by Louis Comfort Tiffany or the museum director’s keychain.

Prozess